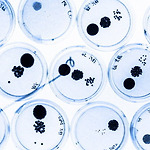

목록헤르페스 (5)
스마트맨의원
 헤르페스 성병 증상, 입술포진 진단받기!
헤르페스 성병 증상, 입술포진 진단받기!
안녕하세요 스마트맨의원입니다. 성기에 자잘하게 수 많은 물집이 생긴다면, 무엇이 문제 일까요?바로 헤르페스 바이러스 감염이 된 경우라고 볼 수 있습니다. 헤르페스는 많은 성병의 종류들 가운데 하나입니다.그렇지만 일반인들은 성병에 대해 잘 모르시는 분들이 많이 계셔서 더 자세하게 설명해드리겠습니다. 헤르페스란 ? 헤르페스는 바이러스에 의해 발생하는 전염성 질환인데요, 1형과 2형으로 나뉘어 있습니다.또 발생하는 부위는 다른 것이 특징입니다. 1형 - 구강 헤르페스로써, 주로 키스를 통해서 전염이 됩니다.대부분의 사람들은 자신이 헤르페스에 걸렸다는 사실을 잘 알지 못하는데요.이를 잘 모르기에 서로 감염되는 경우가 종종 있습니다. 2형 - 성기 헤르페스로써, 성관계를 통해서 전염이 됩니다.특징은 특별한 증상이..
 헤르페스 치료기간 얼마나 될까?
헤르페스 치료기간 얼마나 될까?
안녕하십니까? 스마트맨의원 입니다. 자신의 성기 주변에 물집이 작고 다닥다닥 하게 생겨나고 있는 경우를 발견하신 적이 있으십니까? 이러한 경우에는 헤르페스 바이러스에 감염이 된 것임을 의심을 할 수 있게 되기도 하며, 헤르페스 바이러스를 치료 해야만 합니다. - 헤르페스 바이러스 란? 성기 헤르페스는 문자 그대로 헤르페스에 감염이 된 경우이며, 헤르페스의 원인은 약 95% 정도가 2형 페르페스가 원인 입니다. 그 외의 경우가 바로 1형 바이러스 입니다. 1형 바이러스는 입술 주변에 물집을 만들게 되는 바이러스 이지만, 최근에는 구강성교가 대중화 되게 되면서 많은 분들이 1형에 의한 성기에 물집 증상이 나타나게 되기도 합니다. - 헤르페스 바이러스 잠복 기간은? 평일 약 6일 정도의 잠복기간을 가지게 됩니..
 헤르페스 바이러스 감염
헤르페스 바이러스 감염
안녕하십니까? 스마트맨의원 입니다. 혹시 자신의 성기에 물집이 아주 작고 다닥다닥 붙어 생기고 있는 경우가 있으십니까? 이러한 경우에는 헤르페스 바이러스에 감염이 된 것임을 의심할 수 있게 되기도 합니다. - 헤르페스 바이러스란? 성기 헤르페스는 문자 그대로 헤르페스에 감염이 된 경우이며, 헤르페스의 원인은 약 85%가 2형 헤르페스가 원인 입니다. 나머지 15% 정도가 바로 1형 바이러스 입니다. 이때, 1형 바이러스는 입술 주변에 물집을 만들게 되는 바이러스 이지만, 최근에는 구강성교의 증가로 인해서 많은 분들이 1형에 의한 성기에 물집 증상이 나타나게 되기도 합니다. - 헤르페스 바이러스 잠복 기간은? 평균 약 6일 정도의 잠복기간이 나타나게 됩니다. 하지만, 실제로는 개인차가 존재 하기 때문에 증..
 성기에 물집, 헤르페스 바이러스 증상
성기에 물집, 헤르페스 바이러스 증상
안녕하십니까? 스마트맨의원 입니다. 자신의 성기에 물집이 아주 작고 다닥다닥 붙어 생기고 있으십니까? 이러한 경우에는 헤르페스 바이러스에 감염이 된 것임을 의심할 수 있게 됩니다. - 헤르페스 바이러스란? 성기 헤르페스는 문자 그대로 헤르페스 바이러스에 의한 성기감염 이며, 헤르페스의 원인은 약 85%는 2형 헤르페스가 원인 입니다. 나머지 15%정도가 1형 바이러스 입니다. 이때, 1형 바이러스는 입술 주변에 물집을 만들게 되는 바이러스 이지만, 최근에는 구강 성교의 증가로 인해 1형에 의한 성기에 물집 증상이 나타나게 되면서 성기 헤르페스가 나타나게 됩니다. - 헤르페스 바이러스 잠복기간은? 헤르페스 바이러스에 감염이 된 경우에는 증상이 나타나기 까지의 평균 잠복기간은 약 6일 정도 입니다. 하지만,..
헤르페스 바이러스 증상 알아보자
헤르페스 바이러스 증상 알아보자
남성의 성기에 갑자기 나도 모르는 사이에 작은 물집이 다닥다닥 존재 하게 되는 경우가 있는가? 자신의 성기 또는 구강 내부에 원형의 작은 물집이 많이 나타나게 된다면 헤르페스에 감염이 되었을 수가 있다 ! 그렇다면, 헤르페스에 대해 알아보도록 하자! - 헤르페스 바이러스 란? 성기 헤르페스는 문자 그대로 헤르페스 바이러스에 의한 성기 감염이다. 이러한 헤르페스의 원인의 약 85%는 2형 헤르페스 바이러스가 원인이며, 나머지 15% 정도가 1형 바이러스 이기 때문이다. 이때, 1형 바이러스는 입술 주변에 물집을 만들게 되는 바이러스 이며, 최근 구강 성교의 증가로 인해 1형에 의한 성기 헤르페스가 증가하고 있기도 하다. - 헤르페스 바이러스 잠복기 헤르페스에 감염이 될 경우, 증상이 나타나기 까지의 평균 ..

